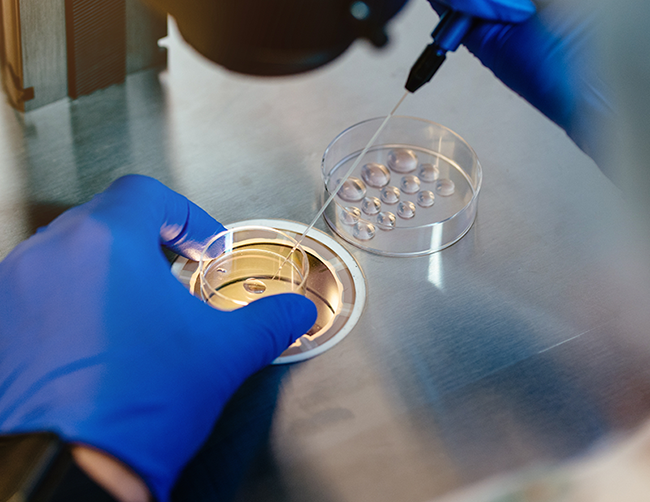

O șansă pentru cuplurile infertile
În cadrul acestui program, Primăria Municipiului București, prin A.S.S.M.B, acorda un sprijin financiar în valoare de maximum 15.000 lei/beneficiar, pentru maximum 2.000 de cupluri sau femei singure infertile din București în perioada 2025 - 2026, în vederea acoperirii costurilor tratamentului medicamentos și al procedurilor de fertilizare in vitro.
Cere o programare
Venim în întâmpinarea pacienților noștri cu:
Consultații in clinică sau online cu experții Fertility Institute, de oriunde te-ai afla. Pentru programări sună la telefon 0219612 sau trimite un e-mail la coordonatorifivcolumna@reginamaria.ro
Pachete de screening gândite special să vă economisească timp, beneficiind atât de investigații medicale necesare în evaluarea statusului fertil, necesare în cadrul oricărei proceduri de FIV, dar și de consilierea unui specialist în infertilitate. Descoperă pachetele aici.
Conditii Program
Domiciliul în Mun. București
Cetățenie română
Vârsta femeii
Recomandare medicală
Participarea la program

Ai alături o echipă de medici cu performanțe dovedite
Încrederea pe care ne-o oferă pacienții care se confruntă cu infertilitatea, trebuie să se întoarcă înzecit către ei. De aceea, medicii noștri se specializează continuu, sunt mereu informați despre soluții noi de tratament și sunt, zi de zi, sprijin pentru pacienți.
Laboratorul nostru de embriologie umană este asistat AI.
Inteligența artificială nu înlocuiește embriologii, ci permite clinicienilor să trateze infertilitatea la cele mai inalte și complexe niveluri:
- Mai puține cicluri FIV. Ajută la evaluarea rapidă și selectarea celor mai viabili embrioni, putând contribui la scăderea numărului de cicluri FIV până la o sarcină.
- Selecție precisă a embrionilor. Algoritmul poate recunoaște foarte precis procesul de maturare al embrionilor, sugerând care embrion are cel mai bun pronostic pentru a se dezvolta într-o sarcină.
- Validare prin AI. Oferă o opinie secundară, de validare, pentru deciziile luate de către embriologi.